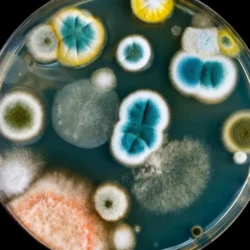

Quantum Leap: Nobel Prize Honors Pioneers of Nanotechnology
Read More
Chemical Conundrum: The Silent Threat of Toxic Chemicals in America’s Homes
Read More
Unlocking the Infinite: The Chemists Crafting Molecules Atom by Atom
Read More
Revolutionizing Cancer Screening: Detecting RNA Biomarkers with Unprecedented Precision
Read More
The Hidden Hazards in Your Wardrobe: How Chemicals in Fashion Could Be Making You Sick
Read More
How New Plastic-Eating Fungi Lead the Charge Against Pollution
Read More